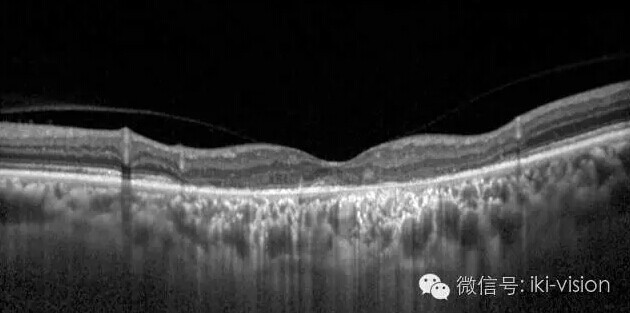
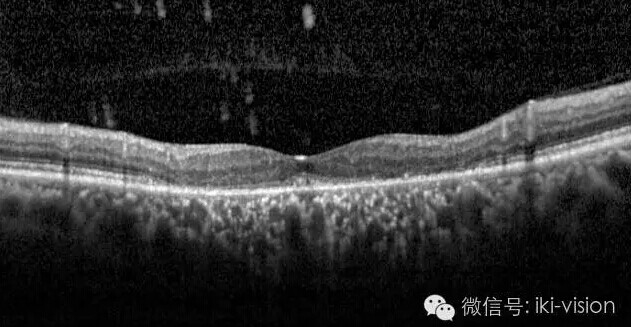

本文转自:NIDEK尼德克
不幸中的万幸
萎缩性AMD患者
☆特别感谢同仁医院史雪辉教授
分享病例☆
患者 男 61岁 裸眼视力
右眼0.2 左眼0.3。

及脱色素

2、自发荧光:可明显看到黄斑
部萎缩灶高荧光

3.OCT检查:右眼(上图)黄斑
中部IS-OS层光反射带消失,外
界膜破坏,RPE萎缩。左眼(下
图)大致同右眼
该患者诊断:双眼萎缩性AMD。
疑问:该患者右眼0.2,左眼0.3
的视力,黄斑中部弥漫性地图萎
缩(GA),OCT显示黄斑中部视
细胞层及RPE层萎缩,难以解释
患者右眼0.2左眼0.3视力。 于是
,我们对患者进行微视野检查(
MP-3),通过对黄斑精准定位的
定量视功能检查,结果发现:


双眼光敏感度在萎缩灶区几乎全
部丧失,但黄斑中心存在着视敏
度,由此说明黄斑中部残留部分
OCT未能明确显示的视细胞——
不幸中的万幸!!!
我们进一步对患者视敏度值分布
进行了模拟分布图评估,结果如
下:


在黄斑萎缩灶以外患者拥有较好
的视敏度区域,黄斑中心保留着
视敏度区域,利用MP-3定位随访
可长期观察这种视功能分布图变
化,中心凹颜色有无变化,中小
凹较好视敏度区域有无变小,及
盲区(红色区域)是否存在改变
,为将来随访萎缩区变化提供形
态及功能的定量基线数据。
MP-3微视野检查:黄斑功能定位
定量分析,实现了更精准的眼底
形态及功能诊断,通过定位随访
,可全面了解患者病情的进展变
化,为眼底病诊断带来更深的认
知。
☆特别感谢同仁医院史雪辉教授
分享病例☆
文 IKI 时广涛 杨亚坤
编辑 IKI 张鹏
更多新闻请点击:


